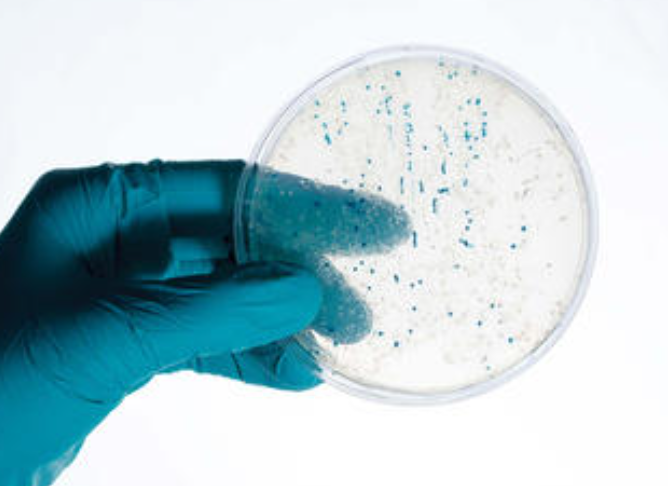

产品名称:
DP101质粒DNA小量提取试剂盒
产品简介:
本产品适合于从1~5ml细菌培养液中提取高达40μg的质粒DNA。实验流程可在20-30分钟内完成,整个操作过程不需接触酚氯仿等有机物抽提,也不需用到耗时的醇类沉淀。本试剂盒采用碱裂解法进行裂解, 通过DNA柱于高盐条件下特异性结合DNA的特点,达到纯化的目的。纯化的质粒可直接用于酶切、PCR、测序、连接、转化和标记等。
产品详情
高效:对菌体内质粒回收效率高于80%
快速:步骤简便,操作流程少,可大大减少质粒提取时间。
纯度高:特殊的体系配合硅胶柱,可得到更高纯度的质粒DNA。
试剂盒回收质粒DNA电泳图

取2ml过夜培养的大肠杆菌,采用试剂盒进行提取,产物经过1%琼脂糖凝胶电泳检测结果。
试剂盒回收质粒DNA稳定性检测数据图

取2ml过夜培养的大肠杆菌,采用试剂盒进行回收,检测试剂盒回收稳定性,结果如图所示,对同一样品
提取效率相当,稳定性好。







评价